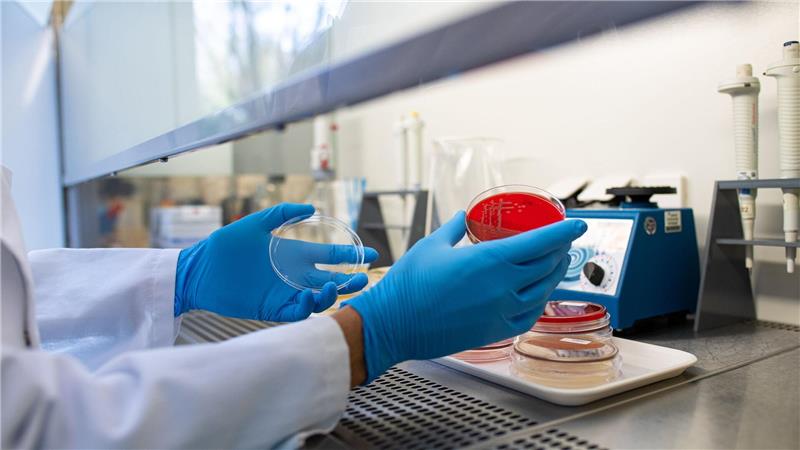
Die Zahl der registrierten Ehec-Infektionen in Mecklenburg-Vorpommern hat sich auf 22 erhöht. (Symbolbild)

Fünf weitere Ehec-Infektionen in Vorpommern
Die Zahl der registrierten Ehec-Infektionen in Mecklenburg-Vorpommern hat sich auf 22 erhöht. (Symbolbild) Foto: Guido Kirchner/dpa
In Mecklenburg-Vorpommern sind jetzt insgesamt 22 Ehec-Infektionen bestätigt. Neue Fälle der schwerwiegenden Folgeerkrankung HUS gab es am Wochenende den Angaben zufolge nicht.
Rostock. Die Zahl der bestätigten Ehec-Infektionen in Mecklenburg-Vorpommern ist über das Wochenende weiter angewachsen. Wie das Landesamt für Gesundheit und Soziales (Lagus) am Montag in Rostock mitteilte, kamen fünf weitere Fälle hinzu. Damit hat sich seit den ersten Erkrankungen Mitte August die Zahl der Betroffenen auf insgesamt nun 22 erhöht, größtenteils Kinder.
Die Infektionen blieben weiterhin auf die Landkreise Vorpommern-Rügen und Vorpommern-Greifswald beschränkt. Dort wurde bei zwei Kindern im Alter von eins bis 13 Jahren und drei Erwachsenen im Alter von 67 bis 79 Jahren die Erkrankung neu diagnostiziert. Zwei der Erwachsenen müssten stationär behandelt werden, hieß es. Weiterhin unklar sind Quelle und Verbreitungswege der gehäuften Ehec-Infektionen im Nordosten.
Entwarnung für Kitakinder in Kavelstorf
Bereits am Samstag hatte der Landkreis Rostock Entwarnung für Kleinkinder aus einer Kindertagesstätte in Kavelstorf gegeben. Dort hatten am Freitag elf Kinder über Erbrechen und teilweise auch Durchfall geklagt. In Stuhlproben der erkrankten Kinder seien Bakterien nachgewiesen worden, die sowohl über Lebensmittel als auch über Tierkontakt übertragen werden können, nicht aber Ehec.
Am Montag habe das Veterinär- und Lebensmittelüberwachungsamt des Kreises Proben aus der Lebensmittelversorgung sowie von Gegenständen in der Kita genommen, um die mögliche Infektionsquelle zu identifizieren. Einige Kinder waren stationär im Krankenhaus behandelt worden. Laut Kreisverwaltung wurden sie zwischenzeitlich wieder entlassen und sind symptomfrei.
Keine neuen Fälle mit hämolytisch-urämischem Syndrom
Wie das Landesgesundheitsamt weiter mitteilte, weisen weiterhin sechs der mit Ehec infizierten Kinder ein hämolytisch-urämisches Syndrom (HUS) auf. Da dies zur Zerstörung der roten Blutkörperchen, Blutgerinnungsstörungen und Funktionsstörungen der Nieren führen kann, werden die Betroffenen in der Regel intensivmedizinisch versorgt. Neue Fälle dieser schwerwiegenden Folgeerkrankung seien am Wochenende nicht hinzugekommen.
Ehec steht für enterohämorrhagische Escherichia coli und bezeichnet bestimmte krankmachende Stämme dieses Darm-Bakteriums, das vor allem bei Wiederkäuern vorkommt. Die Mikroben produzieren sogenannte Shigatoxine: starke Zellgifte, die bei Menschen schwere Durchfallerkrankungen bis hin zu blutigen Durchfällen sowie HUS verursachen können. Kinder sind besonders gefährdet, weil ihr Immunsystem und ihre Organe noch nicht ausgereift sind.


